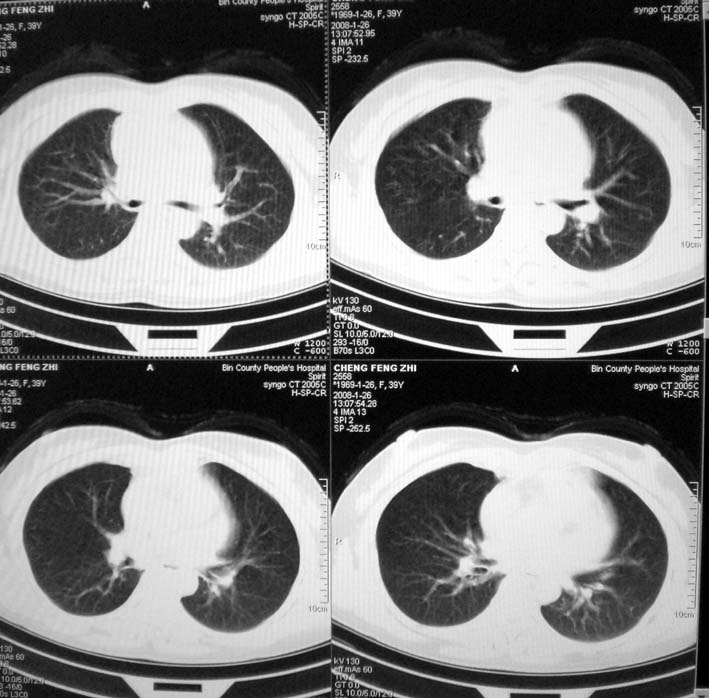

以下是引用卜一在2008-1-27 17:07:00的发言:[br]1)考虑为:淋巴瘤。建议:行进一步检查。2)心包积液。 支持!
以下是引用卜一在2008-1-27 17:07:00的发言:[br]1)考虑为:淋巴瘤。建议:行进一步检查。2)心包积液。 支持!
以下是引用guoke在2008-1-27 14:15:00的发言:[br]纵隔增宽,纵隔内血管境界不清,心包积液,考虑纵隔淋巴瘤.[br]
以下是引用随光逐影在2008-1-27 15:52:00的发言:[br]1)考虑为:淋巴瘤。建议:行进一步检查。2)心包积液。
| 欢迎光临 医影在线 (http://bbs.radida.com/bbs/) | Powered by Discuz! X3.2 |